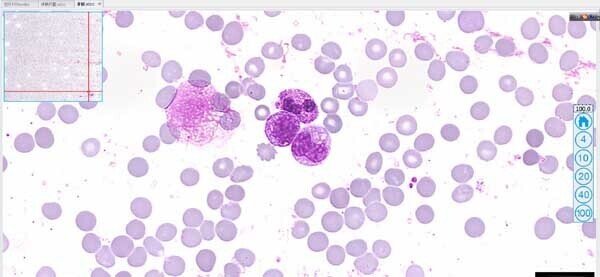
玻片掃描儀2 玻片掃描儀2

玻片掃描儀優(yōu)惠銷售活動!
- 編輯 :
北京長恒榮創(chuàng)科技
時間 : 2017-07-24 23:02 瀏覽量 : 1028
相關(guān)新聞
- 全景熒光玻片掃描成像 02-24
- 奧林巴斯工業(yè)顯微鏡SZ61玉米觀察 02-24
- 奧林巴斯CKX53顯微鏡適合觀察多大尺寸的細(xì)胞 02-23
- 奧林巴斯CKX53顯微鏡適合觀察哪些類型的動物細(xì)胞 02-22
- 奧林巴斯CKX53顯微鏡觀察動物肌肉細(xì)胞 02-21
- 奧林巴斯CX43顯微鏡的相差觀察效果如何 02-21
- 奧林巴斯CKX53顯微鏡觀察動物細(xì)胞 02-21
- 奧林巴斯CX43顯微鏡可以進(jìn)行相差觀察嗎 02-21
- 2025新產(chǎn)品發(fā)布 光影細(xì)胞全新科研級熒光玻片掃描儀上市 02-20
- 奧林巴斯熒光顯微鏡安裝于清華大學(xué)醫(yī)學(xué)院 09-25
- 尼康顯微鏡連接單反相機(jī)安裝于中國農(nóng)業(yè)科學(xué)院 09-25
- 尼康顯微鏡色差的形成 09-24
- 奧林巴斯顯微鏡色差的校正 09-24
- 關(guān)于金相顯微鏡球差的概述 09-24
- 萊卡顯微鏡相散現(xiàn)象概述! 09-24
- 偏光顯微鏡的基礎(chǔ)參數(shù)有哪些? 09-24